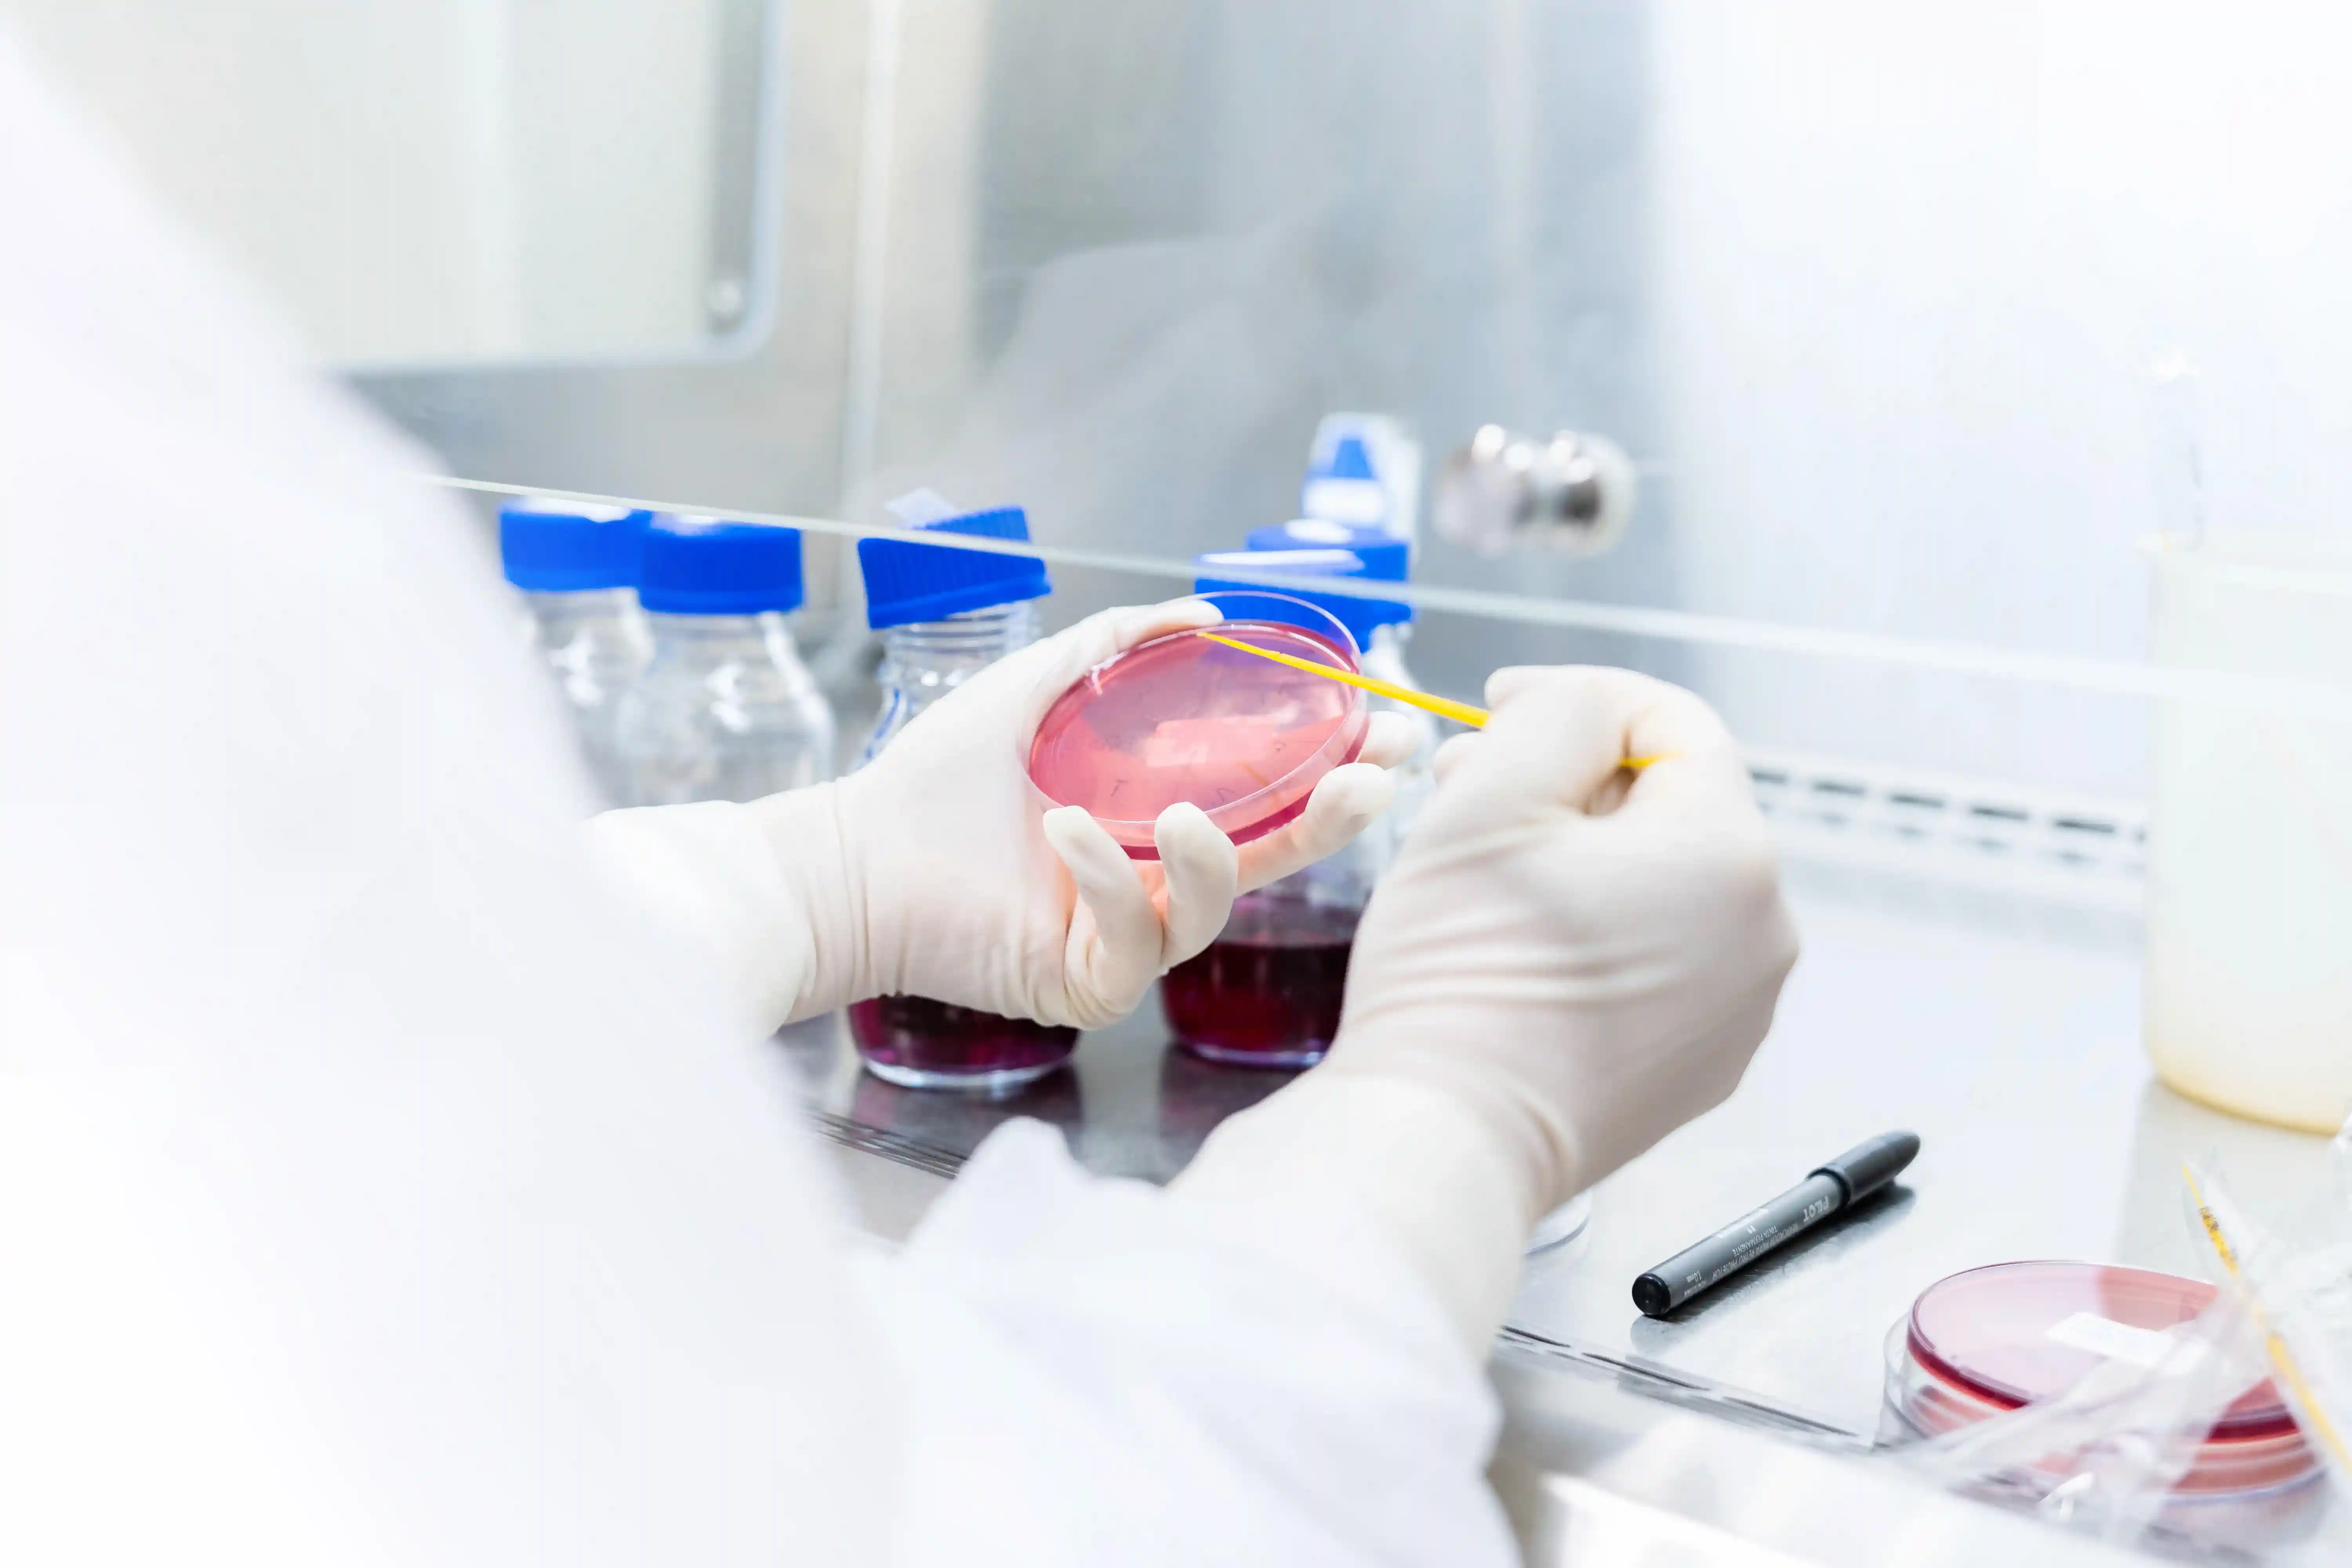
Somos Potência

Our strength
For us, 2023 constituted a period of assessment, strategizing, and forecasting. It was a year of reviewing our history and honoring where we came from and how we got this far. But, above all, of seeing that within us there is the STRENGTH to chart the course to a future that will take us farther. In this report, we talk about this evolution. We will discuss what we have learned and achieved through the restlessness of those who are not afraid to challenge themselves in order to excel. Of innovating to transform.
We are Aché

Our strength in movement
2023 marks the beginning of Aché’s revitalization: we will grow in a sustainable way, aware of our responsibility and impact, seeking to be a reference on every front, with increasingly profitable operations.
Our short-, medium- and long-term strategies are based on three main objectives:
2023 Highlights
Business
Innovation and technology
Environment
Society


1st Place
in the ranking of the most innovative companies in the Pharmaceutical and Life Sciences sector, for the 9th consecutive year.

1st Place
in the Pharmaceutical Industry category.
2023 was the year to reclaim our essence and recognize the power we have to make our business even more agile, profitable and capable of responding to the world’s challenges.
WE ARE ACHÉ
- We are one of 5 major Brazilian pharmaceutical corporations.
- More than 6,000 employees.
- 5 industrial plants, located in São Paulo (capital), Guarulhos (SP), Londrina (PR), Anápolis (GO) and Cabo de Santo Agostinho (PE).
- General warehouse and distribution center, Neolog located in Guarulhos (SP).
- 18 countries covered by the out-licensing agreement: Chile, Colombia, Costa Rica, Ecuador, El Salvador, Guatemala, Honduras, Mexico, Nicaragua, Panama, Paraguay, Peru, Venezuela, Philippines, Japan, Mozambique, Ukraine, Vietnam.
- 351 brands with 906 different uses.
- 152 therapeutic classes.
- 21 medical specialties served.
- 50 products launched in 2023.
- 288,500,000 units produced in 2023.
- 292,500,000 units distributed in 2023.

TOGETHER WE GO FARTHER
In 2023, we invested in structural changes to prepare the company and engage employees for a new cycle of resumed growth.
Our culture has been reflected in practices and tactics that align and mobilize employees toward the future that we are building together.
- New internal communication channels and rituals.
- Succession mapping for directors and their direct employees.
- Review of policies and processes.
- Disclosure and transparency of information and figures.
- Formation of a balanced management team.
- Review of remuneration policies for senior management and other employees.
José Nildo de Oliveira, production operator in the solids area at the Guarulhos plant.
Guilherme Dias, communication coordinator; Denise Alves, administrative assistant; Mariana Gualberto, intellectual property analyst; Leticia Kazumi Sakai, marketing analyst; Juciara Oliveira, buyer; José Mangolin, product manager; Andressa Silva, new business analyst; Orjana Santos, packaging development coordinator; and Leandro Cabral, event coordinator.LiderAché
A movement created to lead this new revitalization cycle at Aché, working on three pillars: resource optimization, revenue generation and people engagement.
It reinforces the process of cultural evolution that we began in 2022 by disseminating a high-performance mindset, focused on delivering results, strategic thinking and the agility needed to overcome obstacles and ensure that all results are achieved.

“We are in the process of revitalizing the company, and this requires everyone to play a leading role and work together, contributing to the goal of retaking leadership in the market without forsaking our essence of caring for people and our Way of Being and Doing, engaging them in the purpose of bringing more life to people.”
Andreia Vitoriano
People and Culture DirectorMore than a strategic direction, innovation has always underpinned Aché’s sustainability and growth.
THE DIVERSITY OF OUR PRODUCTS
More than 200 projects in the company’s pipeline, with 45% of them involving the application of pharmaceutical technologies to resolve the unmet needs of doctors and patients.
Different models of innovation
- → Internal development.
- → Partnerships and licensing agreements with international pharmaceutical companies, such as Vivencia Patch, a transdermal patch for treating Alzheimer’s Disease, which results from a partnership with a Korean company.
- → Partnerships and agreements for licensing and exporting Aché products to countries in Latin America, South Africa, the Philippines and Vietnam.
- → Co-discovery of new drugs and technologies in conjunction with laboratories and universities, such as the collaboration with LNBio (National Bioscience Laboratory), located in Campinas, and a partnership with Unicamp (Campinas State University).

“Aché believes and invests in innovation with quality and safety as one of the main strategic pillars for business growth and sustainability.”
Edson Bernes
Innovation DirectorINNOVATION HIGHLIGHTS
Amazon Biome
Development of products from prospecting in the Amazon biome: one for treating psoriasis and the other for metabolic diseases.
Women’s health
Partnership with the U.S. company Celmatix, which works in women’s health, to develop a drug focused on the treatment of polycystic ovaries.
Radical innovation
→ Innovachem Lab: molecular design and synthesis laboratory for researching new molecules.
→ Bioprospera: an innovation platform based on Brazilian biodiversity that has already led to the launch of the anti-inflammatory Acheflan, with other projects in development, aimed at areas such as dermatology and metabolic diseases.

“The pursuit of ethical proof of efficacy and safety in compliance with all regulatory and quality requirements permeates all stages of our product innovation, research and development processes.”
Stevin Zung
Medical/Scientific DirectorTHE STRENGTH OF OUR OPERATION
Cabo de Santo Agostinho Unit: the path to industry 4.0
- → BRL 800 million invested in its construction.
- → Installed capacity to manufacture 295,000,000 units of products using various technologies.
- → The first unit to make products with orodispersible technology. Unprecedented in the market, these drugs will be sold in the form of sachets with granulated content to be used sublingually and therefore directly absorbed into the bloodstream.
- → MES (Manufacturing Execution System): software that will connect equipment to processes and manage production data.
- → Eight AGVs working as autonomous forklifts, with a sequence of tasks to be performed in an integrated manner with the production process.
- → Automated vertical warehouse: Artificial Intelligence system that learns from the unit’s movements and operations

“With regard to operational excellence, we consider it essential to continually strive for high productivity and technological advances, but without sacrificing eco-efficiency in every stage of the process.”
Paulo Quirino
Director of OperationsOUR DIGITAL TRANSFORMATION
BRL 29,000,000 invested in Digital Transformation in 2023 – twice the amount injected in 2022.
The area was created to support Aché’s revitalization in terms of the skills needed in an increasingly technological market, social and economic context.

“Technological advances and digital transformation will support Aché’s revitalization. We are building new skills, capabilities and solutions that will be very important in an increasingly digital market, social and economic context.”
Rafael Ribeiro
Digital Transformation DirectorThe area was created to support Aché’s revitalization in terms of the skills needed in an increasingly technological market, social and economic context.

Renata Morais, digital marketing manager, and Priscila Harumi Shibata, digital product manager.

Caring for Life
The flagship of Aché’s digital transformation, it offers benefits to patients, such as the possibility of discounts, product subscriptions, information about medications and a patient support program.
- → 15,000,000 consumers by 2023 – 3,100,000 in 2023 alone.
- → 12 million units sold.
- → BRL 994,000,000 in product sales.
- → 34,000 accredited drug stores with sales.

The strength of organization
Transparency, ethics and responsibility are values that we promote on a daily basis and which serve as strengths to drive the revitalization of our business.
SUSTAINABILITY: THE BEGINNING OF A JOURNEY
Our strategy has been strengthened through the implementation of sustainability governance based on the creation and implementation of specific committees, such as the Sustainability Committee, the Social Responsibility Committee and the Diversity, Equity & Inclusion Committee, in addition to the previously existing Ethics and Compliance Committee. Sustainability was also included as a fixed agenda for the Executive Committee of the Board of Directors and part of the monthly agenda for the People and ESG Committee linked to the Administrative Board.
3 topics defined as priorities: Sustainable Supplier Management, Climate Change and Operational Eco-efficiency, broadening the perspective on sustainability across all of the organization’s processes and initiatives.
- → 100% of the electricity purchased at our manufacturing facilities coming from renewable sources.
- → End of sending waste to landfills.
- → 3,361 tons of waste sent for recycling, composting or to a biodigester.

“Our sustainability journey is just beginning. We are facing challenges, but also many opportunities ahead. Ethical relations with all our stakeholders, our climate strategy, management of our supply chain and ongoing pursuit of increasingly eco-efficient operations and processes are the fundamental pillars for the company to be able to grow in a sustainable way.”
Fernanda Bardi
Director of Legal, Compliance and Sustainability.
Edsan Ferro, patient using the Inelatte supplement, and Éder do Amaral, a pharmacist from Farma 22 in Guarulhos/SP.The trust we have established with our various audiences over these 57 years is one of our main strengths.
SOCIETY
Raising awareness about health
Targeted actions related to cholesterol and various mental health pathologies.
Social investment
Definition of social investment guidelines for projects related to health, medical education or healthcare agents, caring for people in socially vulnerable situations and prioritizing projects in the locations of our plants.
DOCTORS: see potential where there are challenges
We partner with doctors along the journey of treating and caring for patients. We deliver solutions in the form of products and build support strategies so that doctors can reach their full potential as health professionals.
Ongoing health education
We have launched a scientific communication department to develop content supported by Artificial Intelligence tools and renowned doctors in their therapeutic areas. We have consolidated the use of WhatsApp and Chatbots to interact with healthcare professionals in a simpler, more streamlined way. Today, doctors can ask their main questions about products in less than a minute via the platform.

“Aché’s partnership with doctors goes beyond delivering solutions in the form of products to also serving as support for doctors to become the best possible healthcare professionals for their patients.”
Wilson Jr
Executive Director of the Prescription UnitCustomers: Aché as a good business partner
An integrated look at the customer improves management and maximizes opportunities. The Commercial Department was redesigned in 2023, bringing together activities such as Sales, Trade Marketing, Supply Management, Merchandising, Customer Service, Management of Indicators and Sales Systems, Market Intelligence, Productivity, Commercial Target Setting and the sales team itself.

Employees: the power of the Aché Generation
We encourage the development of each person’s full potential.
Diversity: cwe consider issues related to Gender Equity, People with Disabilities, Race, LGBTQIA+ and Generations in our choices.
Health: we support physical exercise and healthy diet to promote quality of life for our employees.
Development: we offer training and continuing education programs, such as the Aché Academy, working on individual training and development.
Opportunity:a new cycle of people development, with an emphasis on high performance and meritocracy.
Alessandra da Rocha, José Nildo de Oliveira and Daniel Moreira, operators in the solids area at the Guarulhos plant.The strength of our future
2023 was an intense year. We did a lot. We have learned from our mistakes, adjusted our routes and reinvented ourselves on our quest to be a more agile, profitable and sustainable organization, capable of taking the new leap in growth that we desire.We are clear about where we want to go and the path to follow. We will put all our power into practice to ensure that Aché continues to live up to its purpose of impacting millions of people with better life.